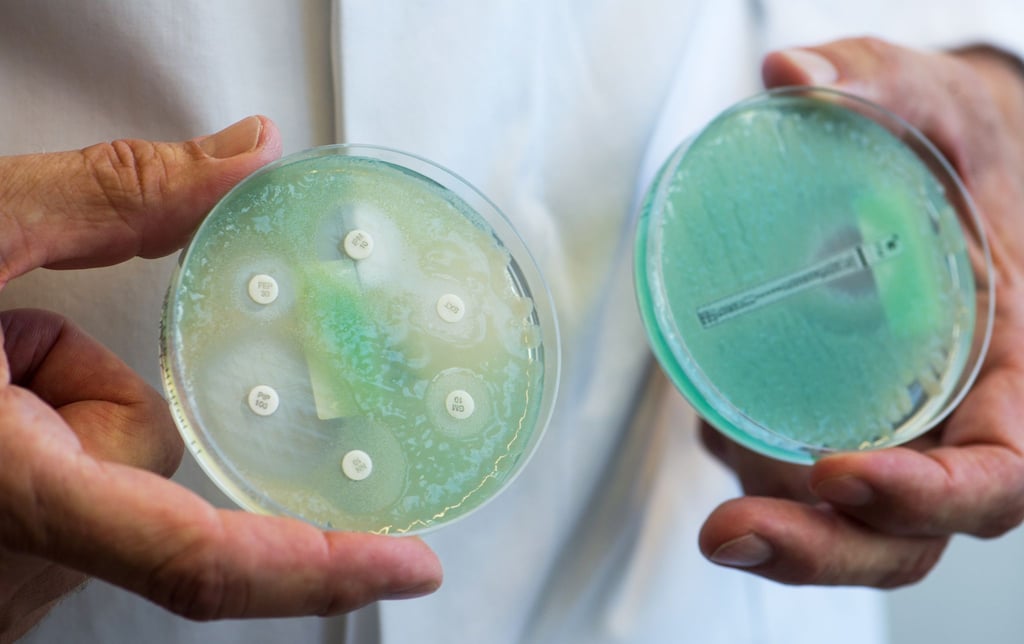
Krankenhauskeime ziehen sich Patienten während ihres Aufenthalts in einer medizinischen Einrichtung oder bei einer ambulanten Behandlung zu. (Archivbild)

Sachsen-Anhalt Weniger Infektionen mit Krankenhauskeim MRSA, aber mehr Tote
Ins Krankenhaus geht, wer gesund werden will. In einigen Fällen kommt es aber zu lebensbedrohlichen Infektionen. Besonders gefürchtet sind multiresistente Keime, gegen die Antibiotika nicht helfen.
Halle - In Sachsen-Anhalt haben sich über die vergangenen Jahre weniger Menschen mit dem Krankenhauskeim MRSA infiziert. 2025 sank die Anzahl der Fälle auf 45, nachdem im Vorjahr noch 49 Fälle gemeldet worden waren. 2020 hatte die Zahl bei 58 gelegen, wie das Landesamt für Verbraucherschutz in Halle auf Anfrage mitteilte. An der Krankheit starben im vergangenen Jahr sieben Personen, wie es weiter hieß. 2024 war es ein Mensch gewesen, im Jahr 2020 zwei.
MRSA steht für Methicillin-resistenter Staphylococcus aureus. Die Bakterien kommen auf der Haut und in den Schleimhäuten vieler gesunder Menschen vor. Erst wenn die Bakterien über Wunden oder durch die Schleimhäute in den Körper gelangen, kann eine Infektion ausbrechen. Da MRSA gegen viele Antibiotika unempfindlich sind, kann eine Erkrankung einen schweren Verlauf - bis zum Tod - nehmen.
Andere Krankenhauskeime kommen immer häufiger vor
„Ausbrüche von MRSA-Infektionen stellen ein ernstes krankenhaushygienisches Problem dar“, erklärt das Robert Koch-Inistitut (RKI). Um etwa einer Infektion und der Ausbreitung entgegenzutreten, sei ein konsequentes und systematisches Hygienemanagement speziell im klinischen Bereich nötig. Das Personal müsse eingehend geschult werden. Infektionen müssten frühzeitig erkannt und Patienten isoliert werden. Auch der kontrollierte Umgang mit Antibiotika gehöre dazu.
MRSA ist bei weitem nicht der einzige Krankenhauskeim. Das RKI erklärte im vergangenen Jahr, die fünf wichtigsten multiresistenten Erreger führten 2022 bundesweit zu etwa 40.000 Infektionen bei medizinischen Behandlungen. Das seien 10.000 mehr als zehn Jahre zuvor gewesen. Ein deutlicher Rückgang sei bei MRSA zu sehen, eine deutliche Zunahme hingegen bei verschiedenen anderen Krankenhauskeimen.




